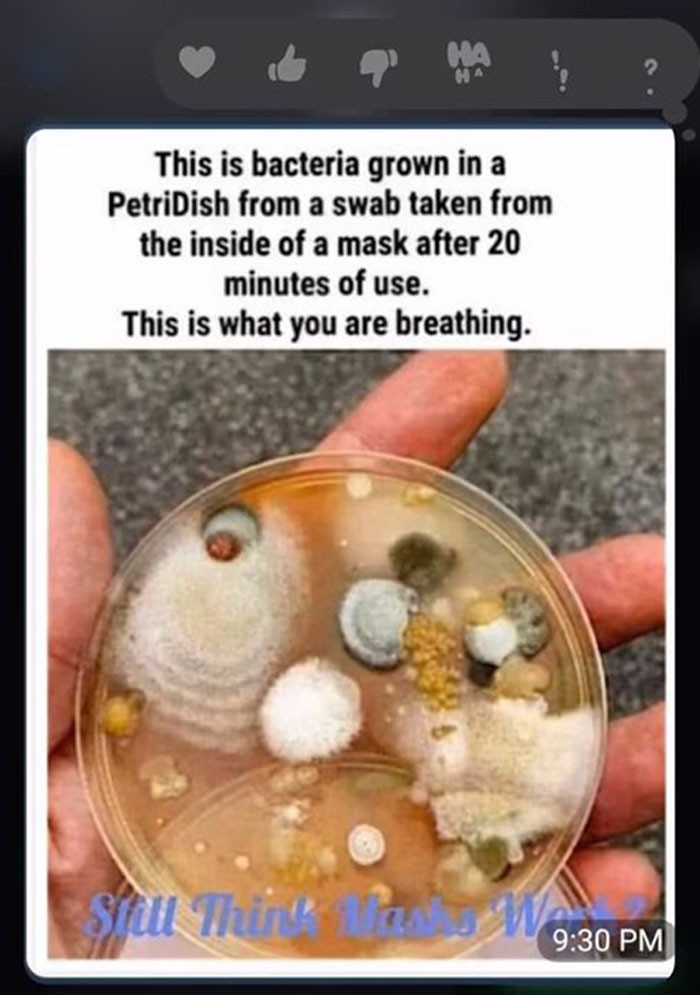
This is her reasoning for not wanting him to wear the mask.

Son Shares 6 Messages From His Mom Who Is A QAnon Follower
TikToker shows some bizarre messages that he's received from his mom, who is a QAnon follower.

One TikTok creator turned a family disagreement into a viral moment after sharing the strange messages his mom keeps sending him. The texts are tied to her QAnon beliefs, and they touch on everything from masks and vaccines to food and water.
For mac1eann, the situation is part frustrating, part unbelievable, because the messages are coming from his own mother. As he posts more of them, viewers get a closer look at just how deep her conspiracy thinking goes, and the comments section quickly becomes its own spectacle.
Here are the messages, plus the reactions they sparked. Read on.
TikTok influencer, mac1eann, went viral with millions of views by sharing the messages that his mom, who's a QAnon follower, sends him.
 Anthony Crider
Anthony CriderSome of the beliefs of QAnon followers are quite strange, as you will see when he starts sharing these messages.
He spends his time sharing messages from his mom with his TikTok followers.
 mac1eann
mac1eannMessage number one is about face masks.
She believes that the masks contain bacteria, and she advises her son not to wear them.
 mac1eann
mac1eann
This is her reasoning for not wanting him to wear the mask.
Her reasoning for wanting him to remove the mask is shown in the photo below. This photo claims to show bacteria swabbed from the inside of a mask, but experts have stated that, based on the appearance of the slide, it could have been incubated and growing for a long time.
This basically means that this isn't necessarily what is on the inside of your mask.
mac1eann
mac1eann
She also doesn't believe in the vaccine and has a strong conviction that whatever is in the vaccine isn't good for us.
 mac1eann
mac1eann
Her messages only get more intense from there.
Again, another crazy thing she's telling her son not to do.
She bombards his phone with more messages, one of which warns him about the tap water. Who knows why she doesn't want him to drink it?
 mac1eann
mac1eann
She doesn't want her son to get a nose swab COVID test.
She tells her son that he shouldn't get a COVID test if it involves a nose swab. She states that this is because they are administering the vaccine when they perform a nose swab.
 mac1eann
mac1eann
This is yet another conspiracy that she believes.
She believes that the food company Senomyx is using aborted baby cells in their food. This isn't true; however, the company does use the cells for research purposes.
 mac1eann
mac1eann
Here's his full TikTok video for those of you interested.
The comments section did not stay quiet for long.
This reminds us of the debate over sharing a family recipe for a cooking competition with the cousin, in this WIBTA thread.
The comments start rolling in, and they probably aren't going in the direction that you'd think.
 queensliwa
queensliwa
People were surprisingly agreeing with her, except on some points.
 basednewyorker
basednewyorker
It seems that other moms have a few beliefs themselves.
 ellie..haggerty
ellie..haggerty
It honestly might not be a bad idea to find out why a lot of adults believe these things.
 4pirate
4pirate
That debate quickly took over the thread.
They don't really realize how wild they sound, but honestly, who knows if they're right or wrong.
 impressionisticpaint
impressionisticpaint
It's good to know that the OP isn't the only one dealing with parents who are deep into Q.
 aliteralpossum
aliteralpossum
I mean, who really knows, though?
 comradenicholas
comradenicholas
Yes, it is partially true, but not in the way that she believes.
 moosematt
moosematt
This must be a super hard situation. I can't imagine the family dinners.
 angie.darling
angie.darling
Eh, for the most part, I'd say so.
 nikki749263825
nikki749263825
This is exactly how crazy they sound.
 yogurtindividual
yogurtindividual
I mean, she's sort of right, but also just a little extreme about it.
 spencil369
spencil369
If you didn't know what QAnon was before, then we're sure you know a bit about it now. I'd say that some beliefs are a little wild, but also nobody really knows what's going on, so we can't completely rule out her beliefs.
What do you think about this, and how would you deal with it?
Want another family blowup, read how OP handled a secret recipe fight with boyfriend’s mom.




